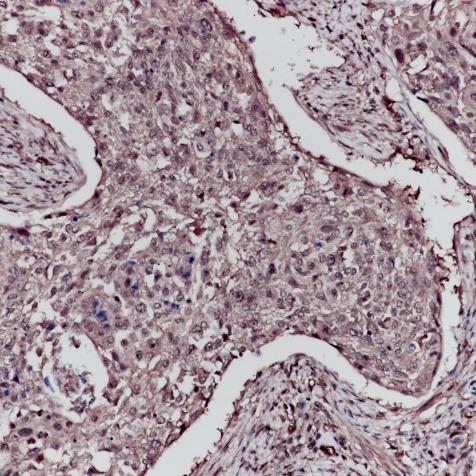

ERK1 Rabbit Monoclonal Antibody(ARA780)
CAT.NO. : ARA6567
RMB Please choose
RMB Please choose
Size:
Trail, Bulk size or Custom requests Please contact us
*产品价格可能会有所调整,请以品牌方官网实时更新的价格为准,以确保准确性。
Background
ERK1 and ERK2 belongs to the protein kinase superfamily. It is involved in both the initiation and regulation of meiosis, mitosis, and postmitotic functions in differentiated cells by phosphorylating a number of transcription factors such as ELK-1. ERK1/2 catalyzed the reaction: ATP + a protein = ADP + a phosphoprotein. It is activated by tyrosine phosphorylation in response to insulin and NGF.
Application
|
Application |
Dilution Ratio |
|
WB |
1:2,000 - 1:10,000 |
|
IHC-P |
1:100 - 1:200 |
|
IP |
1:10 - 1:50 |
|
FC |
1:200 - 1:1,000 |
|
ICC/IF |
1:50 - 1:200 |
Overview
|
Predicted Molecular Weight |
43kDa |
|
Species Cross-reactivity |
Human, Mouse, Rat (Species cross-reactivity determined by WB) |
|
Validated Applications |
WB, IHC-P, IF/ICC, FC, IP |
|
Purity |
ProA affinity purified IgG |
|
Form |
Liquid |
|
Swissprot ID |
P27361 |
|
Immunogen |
A synthetic peptide corresponding to the N-term of ERK1 was used as an immunogen. |
|
Storage Buffer |
PBS 59%, Sodium azide 0.01%, Glycerol 40%, BSA 0.05%. |
Data

All lanes: Anti-ERK1 antibody at 1:2,000 dilution
Predicted MW: 43 kDa
Observed MW: 44 kDa
Lane 1: Hela
Lane 2: 293T
Lane 3: Raw264.7
Lane 4: A431
Lane 5: A375
Lysate at 10 μg per lane
2nd Ab: GAR HRP(H+L) 1:5,000
Exposure: 50s

All lanes: Anti-ERK1 antibody at 1:2,000 dilution
Predicted MW: 43 kDa
Observed MW: 44 kDa
Lane 1: Mu Brain
Lane 2: Mu Kidney
Lane 3: Mu Liver
Lane 4: Rat Brain
Lane 5: Rat Kidney
Lysate at 10 μg per lane
2nd Ab: GAR HRP(H+L) 1:5,000
Exposure: 20s

Immunohistochemistry (Formalin/PFA-fixed paraffin paraffin-embedded sections) analysis Cervix cancer tissue labelling ERK1 with ERK1 Rabbit Monoclonal Antibody(ARA780)

ERK1 Rabbit Monoclonal Antibody(ARA780) staining ERK1 in Hela cells by IF/ICC (immunofluorescence/immunocytochemistry).
Cells were fixed with paraformaldehyde, permeabilized with 0.1% Triton X-100 and blocked with 10% goat serum for half an hour at room temperature.
Samples were incubated with primary antibody (1:50) at 4°C.
An Alexa Fluor® 488-conjugated Goat Anti-Rabbit IgG polyclonal was used as the secondary antibody (1:500).
DAPI (blue) was used as the nuclear counter stain.
Control: PBS and secondary antibody, An Alexa Fluor® 488-conjugated Goat Anti-Rabbit IgG (1:500).

Overlay histogram showing Hela cells stained with ERK1 Rabbit Monoclonal Antibody(ARA780) (Red).
The cells were fixed with 4% paraformaldehyde (10 min) and then permeabilized with 0.1% TritonX-100 for 15 min.
The cells were then incubated in the antibody (ERK1 Rabbit Monoclonal Antibody(ARA780), 1:1,000 dilution) in 1x PBS/1% BSA for 30 min at room temperature.
The secondary antibody used was a Goat Anti-Rabbit Alexa Fluor® 488 (IgG H+L) at 1:2,000 dilution for 20 min at room temperature.
Unlabelled sample (Black) was used as a control.

ERK1 was immunoprecipitated from 0.4mg of A375 whole cell lysate with ERK1 Rabbit Monoclonal Antibody(ARA780) at 1:50 dilution.
2nd Ab:
GAR HRP for IP 1:500
Lane 1: ERK1 Rabbit Monoclonal Antibody(ARA780) IP in A375 whole cell lysate
Lane 2: PBS instead of ERK1 Rabbit Monoclonal Antibody(ARA780) in A375 whole cell lysate
Lane 3: A375 whole cell lysate, 10 μg (input)
Exposure: 120s
Storage
Store at 4°C short term. For long term storage, store at -20°C, avoiding freeze/thaw cycles.
Research Use Only
For Research Use Only. Not for use in diagnostic procedures.
 New Products
New Products